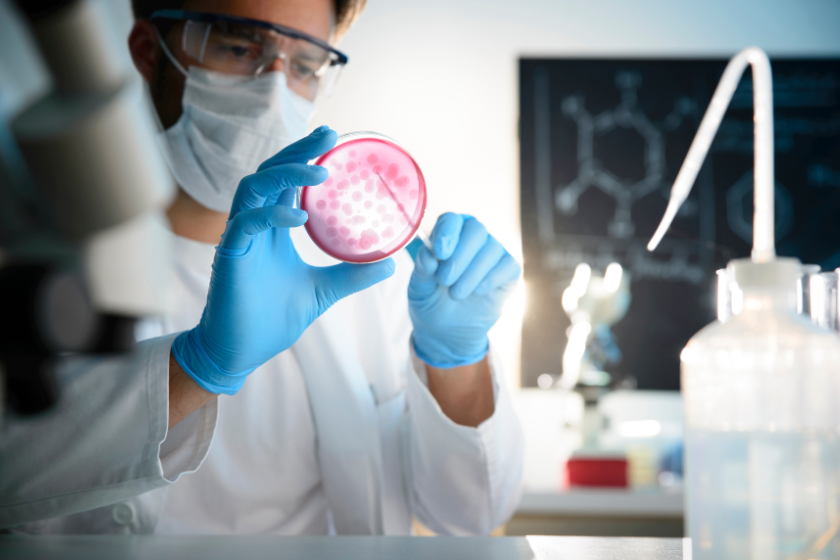

El cultivo y sensibilidad es una técnica de laboratorio utilizada en microbiología para identificar organismos patógenos (como bacterias, hongos o virus) en muestras biológicas y determinar su susceptibilidad a diversos antibióticos o antimicrobianos. Este procedimiento es esencial para el diagnóstico y tratamiento adecuado de infecciones.
Un cultivo y sensibilidad es una prueba de laboratorio que se realiza para identificar microorganismos, como bacterias o hongos, presentes en una muestra biológica (por ejemplo, sangre, orina, esputo). Esta prueba también determina la sensibilidad de estos microorganismos a diferentes antibióticos o antifúngicos, ayudando a guiar el tratamiento adecuado.
La prueba comienza con la recolección de una muestra del paciente, que puede ser de sangre, orina, secreciones, o tejido infectado. La muestra se coloca en un medio de cultivo en condiciones controladas para permitir que los microorganismos crezcan. Después de un período de incubación, se realizan pruebas adicionales para determinar a qué medicamentos son sensibles o resistentes.
Los resultados de un cultivo pueden tardar de 24 a 48 horas, aunque en algunos casos puede ser más tiempo, dependiendo del tipo de microorganismo y el medio de cultivo utilizado. Los resultados de la prueba de sensibilidad suelen estar disponibles un par de días después de que se ha identificado el organismo, ya que requieren pruebas adicionales.
Si se identifica un microorganismo resistente, es importante que tu médico evalúe los resultados y ajuste el tratamiento. Puede ser necesario utilizar un antibiótico diferente al que inicialmente se prescribió. También se puede considerar una consulta con un especialista en enfermedades infecciosas para discutir las opciones de tratamiento más efectivas.